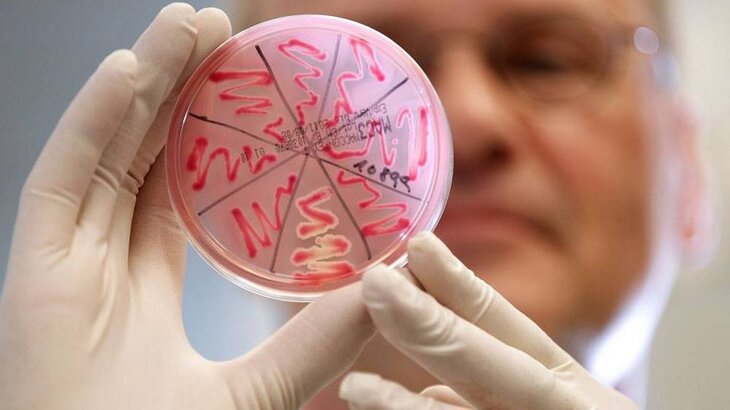

Фото: facebook.com/premia.prosvetitel
Для всех, кто любит науку и научно-популярную литературу с 12 по 15 ноября в Москве пройдет интеллектуальный Фестиваль премии "Просветитель". В течение четырех дней можно будет попасть на лекцию о неизведанном Плутоне, научиться читать газеты между строк, увидеть изнутри Российский квантовый центр, посчитать сверчков в зоопарке и поучаствовать в викторине с учеными – всего 18 событий, которые интересно посетить каждому. Мы выбрали для вас самые интересные.
Карлик Плутон и его свита

Фото: facebook.com/premia.prosvetitel
В 1930 году Клайд Томбо открыл Плутон, который до недавнего времени считался девятой планетой Солнечной системы и долго оставался совершенно неисследованным. На лекции, которая пройдет 13 ноября в Московском планетарии, астроном, доцент физического факультета МГУ Владимир Сурдин расскажет о том, что долгие годы мешало изучению Плутона, почему его изгнали из семьи планет Солнечной системы, что такое пояс Койпера и как Плутон стал прототипом нового класса небесных тел.
Время: 13 ноября, 19:00
Вход по предварительной регистрации
Проблемы на пути создания квантового компьютера

Фото: facebook.com/premia.prosvetitel
Квантовые компьютеры, основанные на использовании эффектов квантовой механики, могут решать задачи, которые невозможно решить на обычных компьютерах. Сегодня ученые уже получили основные компоненты для таких компьютеров – квантовые биты или кубиты. Однако многие проблемы до сих пор остаются нерешенными. О них расскажет профессор экспериментальной физики, доктор физико-математических наук Алексей Устинов. Лекция-экскурсия, подготовленная совместно с "Курилкой Гуттенберга", пройдет в Российском квантовом центре в Сколково.
Время: 14 ноября, 16:00
Вход по предварительной регистрации
Инфекции. История трагедий и побед
Фото: facebook.com/premia.prosvetitel
В библиотеке им. А.П.Чехова пройдет беседа Анжелики Сергеевой и Николая Саперкина с журналистом Светланой Рейтер, посвященная этическим границам эпидемиологи и иммунологи. Авторы книги "Инфекции. История трагедий и побед" расскажут, как ученым разных эпох удавалось убеждать человека в своей правоте и почему им приходится ставить эксперименты на людях.
Время: 14 ноября, 18:00, вход свободный
Как читать газеты?

Фото: facebook.com/premia.prosvetitel
5 ученых из разных областей науки – экономист, лингвист, социолог, политолог и философ за 1,5 часа покажут, как их профессиональные навыки помогают им понимать, казалось бы, и так понятные газетные тексты, видеть в них скрытые от неподготовленного читателя смыслы и распознавать вольные или невольные манипуляции. Мастер-класс с Максимом Кронгаузом, Алексеем Левинсоном, Вадимом Новиковым, Екатериной Шульман и Кириллом Мартыновым пройдет в Лектории Музея при поддержке проекта InLiberty.
Время: 14 ноября, 19:00, вход свободный
Один день с... зоотехником

Фото: facebook.com/premia.prosvetitel
Не все знают, что в центре города, в одном из обширных, похожих на лабиринт подвалов зоопарка, есть комната, где каждый день рождается тысяча сверчков. Не обращая внимания на чудовищный грохот их стрекотания, сотрудник зоопарка Алла делает свою работу: готовит изысканные корма для насекомых, ухаживает за яйцами и личинками, чистит контейнеры – она не имеет права на малейшую ошибку. Ведь если сверчки заболеют, и в очередной коробочке не вылупятся яйца, без еды останутся одни из самых уникальных и красивых жителей зоопарка: изумрудные задумчивые агамы, шустрые обезьянки-мармозетки, редчайшие кафрские вороны, смертельно ядовитые лягушки-древолазы. Участники экскурсии узнают все секреты размножения сверчков, а при желании получат их для самостоятельных экспериментов дома.
Так как количество мест на интерактивной экскурсии Ильи Колмановского ограничено, то приглашение на нее получат дети, наиболее интересно ответившие на следующий вопрос: "В зоопарке много птиц и зверей, которых кормят сверчками; но это некрупные животные. Почему на свете нет животных ростом со слона, которые бы питались насекомыми?"
Ответы нужно присылать по адресу p.prosvetitel@gmail.com
Время: 15 ноября, два сеанса: для детей 8-12 лет, 10:30; для детей 12+, 12:00
Вход по результатам викторины
Реликвии повседневности

Фото: facebook.com/premia.prosvetitel
Все вещи, которые нас окружают, отражают чью-то частную судьбу, а вместе они представляют ту повседневность, из которой и складывается большая история. Журналист Юрий Сапрыкин и исследователь повседневности Татьяна Дашкова – расскажут о культуре советского быта на примере вещей, которые на мероприятие принесут гости фестиваля и участники проекта Relikva.
Время: 15 ноября, 20:00, вход свободный
Контрольная!

Фото: facebook.com/premia.prosvetitel
В финальный день фестиваля в ГМИИ им. А.С.Пушкина пройдет викторина по мотивам премии "Просветитель", в которой смогут принять участие как сами номинанты на премию, так и все желающие, все, кому нравится несерьезный интеллектуальный досуг. Вопросы викторины потребуют не специальных знаний, а только сообразительности и быстроты реакции. Поэтому все участники окажутся в равных условиях: каждого ждет масса веселья, призов и интеллектуальных мук.
Время: 15 ноября, сбор гостей – 19:30, начало – 20:00
Цена: 500 руб. Билеты – в продаже в кассах музея. Внимание! Количество билетов ограничено.
Полную программу можно найти на сайте фестиваля премии "Просветитель"








Собянин: началось строительство крупнейшего в России электродепо



























